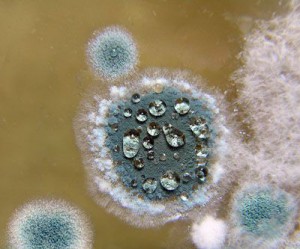
пенициллин

Кому принадлежит открытие пенициллина?
Вопреки всеобщему убеждению, сэр Александр Флеминг значится далеко в конце списка.
Вопреки всеобщему убеждению, сэр Александр Флеминг значится далеко в конце списка.
Вот уже более тысячи лет бедуины в Северной Африке готовят целебную мазь из плесени, которую соскребают с ослиных упряжей.
В 1897 году молодой военврач из Лиона по имени Эрнст Дюшен сделал «открытие», наблюдая за тем, как арабские мальчишки‑конюхи применяют плесень с еще сырых седел для обработки ран на спинах лошадей, натертых этими же самыми седлами.
Дюшен тщательно исследовал взятую плесень, определил ее как Penicillium glaucum, опробовал на морских свинках для лечения тифа и обнаружил ее разрушающее действие на бактерии Escherichia coli. Это было первое в истории клиническое испытание того, что вскоре станет известным всему миру пенициллином.
Молодой человек представил результаты своих исследований в виде докторской диссертации, настойчиво предлагая продолжить работу в данной области, однако парижский Институт Пастера не удосужился даже подтвердить получение документа – видимо, потому, что Дюшену было всего двадцать три, да и вообще, чего путного может написать никому не известный студентик военно‑медицинского училища?
Впоследствии в дело вмешался армейский долг, и в 1912 году Дюшен умер в безвестности от туберкулеза – болезни, которую вскоре победят с помощью его же открытия.
Заслуженная слава пришла к Дюшену уже после смерти, в 1949 году, – через пять лет после того, как сэр Александр Флеминг был удостоен Нобелевской премии за открытие (уже в третий раз) антибиотического эффекта пенициллина.
Термин «пенициллин» был придуман Флемингом в 1929 году. По счастливой случайности, явившейся результатом стечения ряда обстоятельств, столь невероятных, что в них почти невозможно поверить{6}, ученый обратил внимание на антибактериальные свойства плесени, которую он определил как Penicillium rubrum. Как выяснилось, определение Флеминга оказалось неверным. Лишь через много лет Чарльз Том откорректировал его оценку и дал грибку правильное название – Penicillum notatum.
Данная плесень изначально именовалась Penicillium из‑за того, что под микроскопом ее спороносные лапки выглядели как крошечные кисточки. А по‑латыни кисточка для письма называлась penicillum – то же самое слово, от которого происходит английское «pencil» («карандаш»). Хотя на деле клетки плесени Penicillum notatum скорее напоминают нечто совсем иное и более жуткое – кистевые кости человеческого скелета. Довольно показательную фотографию этого грибка можно увидеть на сайте по адресу: http://botit.botany.wisc.edu/Toms_fungi/nov2003.html.
Известные виды сыра – такие, как «Стилтон», «Рокфор», «Дейниш блю», «Горгонзола», «Камамбер», «Лимбургер» и «Бри», – содержат пенициллин.